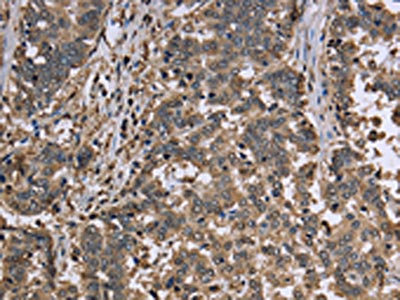

GAPDH Antibody
-
中文名稱:GAPDH兔多克隆抗體
-
貨號:CSB-PA779821
-
規(guī)格:¥1100
-
圖片:
-
The image is immunohistochemistry of paraffin-embedded Human liver cancer tissue using CSB-PA779821(GAPDH Antibody) at dilution 1/30. (Original magnification: ×200)
-
The image is immunohistochemistry of paraffin-embedded Human colon cancer tissue using CSB-PA779821(GAPDH Antibody) at dilution 1/30. (Original magnification: ×200)
-
Gel: 8%SDS-PAGE, Lysate: 20 μg, Lane 1-2: 293T cells, Hela cells, Primary antibody: CSB-PA779821(GAPDH Antibody) at dilution 1/1000, Secondary antibody: Goat anti rabbit IgG at 1/8000 dilution, Exposure time: 15 seconds
-
-
其他:
產(chǎn)品詳情
-
Uniprot No.:
-
基因名:
-
別名:38 kDa BFA-dependent ADP-ribosylation substrate antibody; aging associated gene 9 protein antibody; Aging-associated gene 9 protein antibody; BARS-38 antibody; cb609 antibody; EC 1.2.1.12 antibody; Epididymis secretory sperm binding protein Li 162eP antibody; G3P_HUMAN antibody; G3PD antibody; G3PDH antibody; GAPD antibody; GAPDH antibody; Glyceraldehyde 3 phosphate dehydrogenase antibody; glyceraldehyde 3-PDH antibody; Glyceraldehyde-3-phosphate dehydrogenase antibody; HEL-S-162eP antibody; KNC-NDS6 antibody; MGC102544 antibody; MGC102546 antibody; MGC103190 antibody; MGC103191 antibody; MGC105239 antibody; MGC127711 antibody; MGC88685 antibody; OCAS; p38 component antibody; OCT1 coactivator in S phase; 38-KD component antibody; peptidyl cysteine S nitrosylase GAPDH antibody; Peptidyl-cysteine S-nitrosylase GAPDH antibody; wu:fb33a10 antibody
-
宿主:Rabbit
-
反應(yīng)種屬:Human,Mouse,Rat
-
免疫原:Fusion protein of Human GAPDH
-
免疫原種屬:Homo sapiens (Human)
-
標(biāo)記方式:Non-conjugated
-
抗體亞型:IgG
-
純化方式:Antigen affinity purification
-
濃度:It differs from different batches. Please contact us to confirm it.
-
保存緩沖液:-20°C, pH7.4 PBS, 0.05% NaN3, 40% Glycerol
-
產(chǎn)品提供形式:Liquid
-
應(yīng)用范圍:ELISA,WB,IHC
-
推薦稀釋比:
Application Recommended Dilution ELISA 1:1000-1:10000 WB 1:1000-1:10000 IHC 1:50-1:200 -
Protocols:
-
儲存條件:Upon receipt, store at -20°C or -80°C. Avoid repeated freeze.
-
貨期:Basically, we can dispatch the products out in 1-3 working days after receiving your orders. Delivery time maybe differs from different purchasing way or location, please kindly consult your local distributors for specific delivery time.
-
用途:For Research Use Only. Not for use in diagnostic or therapeutic procedures.
相關(guān)產(chǎn)品
靶點(diǎn)詳情
-
功能:Has both glyceraldehyde-3-phosphate dehydrogenase and nitrosylase activities, thereby playing a role in glycolysis and nuclear functions, respectively. Glyceraldehyde-3-phosphate dehydrogenase is a key enzyme in glycolysis that catalyzes the first step of the pathway by converting D-glyceraldehyde 3-phosphate (G3P) into 3-phospho-D-glyceroyl phosphate. Modulates the organization and assembly of the cytoskeleton. Facilitates the CHP1-dependent microtubule and membrane associations through its ability to stimulate the binding of CHP1 to microtubules. Component of the GAIT (gamma interferon-activated inhibitor of translation) complex which mediates interferon-gamma-induced transcript-selective translation inhibition in inflammation processes. Upon interferon-gamma treatment assembles into the GAIT complex which binds to stem loop-containing GAIT elements in the 3'-UTR of diverse inflammatory mRNAs (such as ceruplasmin) and suppresses their translation. Also plays a role in innate immunity by promoting TNF-induced NF-kappa-B activation and type I interferon production, via interaction with TRAF2 and TRAF3, respectively. Participates in nuclear events including transcription, RNA transport, DNA replication and apoptosis. Nuclear functions are probably due to the nitrosylase activity that mediates cysteine S-nitrosylation of nuclear target proteins such as SIRT1, HDAC2 and PRKDC.
-
基因功能參考文獻(xiàn):
- This suggests that RX624 might be useful as a drug against polyglutamine pathologies, and that is could be administered exogenously without affecting target cell physiology. This protective effect was validated by the similar effect of an anti-GAPDH specific antibody. PMID: 28450110
- GAPDH can interact with proteins participating in DNA repair, such as APE1, PARP1, HMGB1, and HMGB2. In this review, the functions of GAPDH associated with DNA repair are discussed in detail. PMID: 28601074
- Nitric oxide-induced GAPDH aggregation specifically induces mitochondrial dysfunction via permeability transition pore opening, leading to cell death. PMID: 28167533
- GAPDH may act as a chaperone in heme transfer to downstream areas PMID: 28315300
- NAD(+) inhibited both GAPDH aggregation and co-aggregation with GOSPEL, a hitherto undescribed effect of the coenzyme against the consequences of oxidative stress. PMID: 27282776
- Monoclonal Antibodies DSHB-hGAPDH-2G7 and DSHB-hGAPDH-4B7 Against Human Glyceraldehyde-3-Phosphate Dehydrogenase. PMID: 27556912
- the present study suggests that GAPDH plays an important role in cancer metastasis by affecting EMT through regulation of Sp1-mediated SNAIL expression. PMID: 27878251
- Knockdown of LAMP2A, a CMA-related protein, and TSG101, an mA-related protein, significantly but only partially decreased the punctate accumulation of GAPDH-HT in AD293 cells and primary cultured rat cortical neurons. PMID: 27377049
- In conclusion, the data show that two GAPDH binders could be therapeutically relevant in the treatment of injuries stemming from hard oxidative stress. PMID: 26748070
- transient silencing of GAPDH reduces intracellular ROS and facilitates increased autophagy, thereby reducing acute hypoxia and reoxygenation injury as well as the resulting apoptosis and necrosis. PMID: 26279122
- This review will summarize our current understanding of GAPDH-mediated regulation of RNA function PMID: 26564736
- analysis of PSCA level in the peripheral blood of PC patients who underwent radical prostatectomy shows it is related to a GADPH reference level (PSCA/GAPDH ratio) PMID: 26527100
- In 60 % of patients with type 2 diabetes, a reversible inhibition of GAPDH is observed. PMID: 25189828
- The results of this study led us to conclude that in cancer cells constantly exposed to conditions of oxidative stress, the protective power of Hsp70 should be abolished by specific inhibitors of Hsp70 expression. PMID: 26713364
- GAPDH and protoporphyrinogen oxidase were shown to have higher expression in faster growing cell lines and primary tumors. Pharmacologic inhibition of GAPDH or PPOX reduced the growth of colon cancer cells in vitro PMID: 25944804
- The levels of GAPDH protein were significantly up-regulated in lung squamous cell carcinoma tissues and elevated GAPDH expression is associated with the proliferation and invasion of lung and esophageal squamous cell carcinomas. PMID: 25944651
- Genetic variants in GAPDH confer susceptibility to sporadic Parkinson's disease in a Chinese Han population. PMID: 26258539
- Data revealed that GAPDH is a phosphorylation substrate for AMPK and its interaction with Sirt1 in the nucleus. The phosphorylation and the nuclear translocation of GAPDH mediate rapid Sirt1 activation and autophagy initiation under glucose deprivation. PMID: 26626483
- findings demonstrate that dissociation of the GAPDH/Siah1 pro-apoptotic complex can block high glucose-induced pericyte apoptosis, widely considered a hallmark feature of diabetic retinopathy PMID: 26438826
- Extracellular GAPDH, or its N-terminal domain, inhibited gastric cancer cell growth. GAPDH bound to E-cadherin and downregulated the mTOR-p70S6 kinase pathway. PMID: 25785838
- suggests that GAPDH aggregates accelerate Abeta amyloidogenesis, subsequently leading to mitochondrial dysfunction and neuronal cell death in the pathogenesis of AD PMID: 26359500
- The level of GAPDH-AP DNA adduct formation depends on oxidation of the protein SH-groups; disulfide bond reduction in GAPDH leads to the loss of its ability to form the adducts with AP DNA PMID: 26203648
- The activity of GAPDS was significantly positively correlated with sperm motility and negatively with the incidence of infertility. PMID: 26255202
- The N terminus of nuclear GAPDH binds with PARP-1, and this complex promotes PARP-1 overactivation both in vitro and in vivo. PMID: 25882840
- deregulated GAPDH expression promotes NF-kappaB-dependent induction of HIF-1alpha and has a key role in lymphoma vascularization and aggressiveness PMID: 25394713
- analysis of how flux through GAPDH is a limiting step in aerobic glycolysis PMID: 25009227
- astrocytic production of D-serine is modulated by glycolytic activity via interactions between GAPDH and SRR. PMID: 25870284
- Dimer and tetramer interface residues in adenine-uridine rich elements are important for GAPDH-RNA binding. PMID: 25451934
- Siah1 is a substrate of ASK1 for activation of the GAPDH-Siah1 oxidative stress signaling cascade. PMID: 25391652
- GAPDH expression is deregulated during melanoma progression. PMID: 25550585
- Oxidation of an exposed methionine instigates the aggregation of glyceraldehyde-3-phosphate dehydrogenase. PMID: 25086035
- MZF-1 binds to and positively regulates the GAPDH promoter, indicating a role for GAPDH in calcitriol-mediated signaling. PMID: 25065746
- The protein encoded by this gene contains a peptide that displays antimicrobial activity against E. coli, P. aeruginosa, and C. albicans. PMID: 22832495
- GAPDH gene over expression in resected tumor samples is an adverse prognostic factor in non small cell lung cancer. PMID: 23988223
- This review describes the structure and localization of GAPDH in cells as well as the latest discoveries on the multifunctional properties of the enzyme. PMID: 24018444
- TG2-dependent GAPDH deamidation was suggested to participate in actin cytoskeletal remodeling. PMID: 24375405
- acetylation of GAPDH (K254) is reversibly regulated by the acetyltransferase PCAF and the deacetylase HDAC5. PMID: 24362262
- GAPDH binds to active Akt, leading to Bcl-xL increase and escape from caspase-independent cell death. PMID: 23645209
- GAPDH is a moonlighting protein that functions as a glycolytic enzyme as well as a uracil DNA glycosylase. PMID: 20727968
- Results indicate that CIB1 is uniquely positioned to regulate PI3K/AKT and MEK/ERK signaling and that simultaneous disruption of these pathways synergistically induces a nuclear GAPDH-dependent cell death. PMID: 22964641
- The data presented demonstrate that up-regulation of GAPDH positively associated genes is proportional to the malignant stage of various tumors and is associated with an unfavourable prognosis. PMID: 23620736
- In a yeast two-hybrid screen of a heart cDNA library with Mst1 as bait, glyceraldehyde-3-phosphate dehydrogenase (GAPDH) was identified as an Mst1-interacting protein. PMID: 23527007
- interaction between prolyl oligopeptidase and glyceraldehyde-3-phosphate dehydrogenase is required for cytosine arabinoside-induced glyceraldehyde-3-phosphate dehydrogenase nuclear translocation and cell death PMID: 23348613
- NleB, a bacterial glycosyltransferase, targets GAPDH function to inhibit NF-kappaB activation. PMID: 23332158
- GAPDH binds to alkylated, single-stranded, double-stranded and telomeric sequences in a drug-dependent and DNA sequence/structure-dependent manner. PMID: 23409959
- GAPDH negatively regulates HIV-1 infection and provide insights into a novel function of GAPDH in the HIV-1 life cycle and a new host defense mechanism against HIV-1 infection. PMID: 23237566
- The strength, selectivity, reversibility, and redox sensitivity of heme binding to GAPDH are consistent with it performing heme sensing or heme chaperone-like functions in cells. PMID: 22957700
- The ability of C1q to sense both human and bacterial GAPDHs sheds new insights on the role of this important defense collagen molecule in modulating the immune response. PMID: 23086952
- SIRT1 functions to retain GAPDH in the cytosol, protecting the enzyme from nuclear translocation via interaction with these two proteins. PMID: 22789853
- The present mini review summarizes recent findings relating to the extraglycolytic functions of GAPDH and highlights the significant role this enzyme plays in regulating both cell survival and apoptotic death--{REVIEW} PMID: 21895736
顯示更多
收起更多
-
亞細(xì)胞定位:Cytoplasm, cytosol. Nucleus. Cytoplasm, perinuclear region. Membrane. Cytoplasm, cytoskeleton.
-
蛋白家族:Glyceraldehyde-3-phosphate dehydrogenase family
-
數(shù)據(jù)庫鏈接:
Most popular with customers
-
YWHAB Recombinant Monoclonal Antibody
Applications: ELISA, WB, IHC, IF, FC
Species Reactivity: Human, Mouse, Rat
-
Phospho-YAP1 (S127) Recombinant Monoclonal Antibody
Applications: ELISA, WB, IHC
Species Reactivity: Human
-
-
-
-
-
-